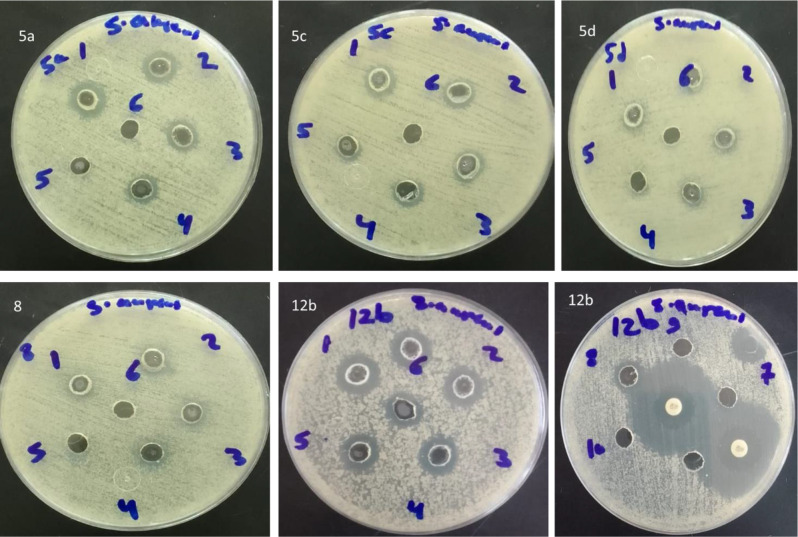
Fig. 4

Abstract
A ring annelation reaction was used to successfully prepare benzo[4,5]imidazo[1,2-a][1,3,5]triazines (Systematic Name: 1,3,4a,9-tetraza-4H-fluoren-2-amines) tethered to phenoxy-N-arylacetamide, pyrazole, and 2-(4-(1-phenyl-1H-pyrazol-3-yl)phenoxy)-N-arylacetamide moieties utilizing 1-(1H-benzo[d]imidazol-2-yl)guanidine and the proper aldehydes as precursors. 2-(Phenylamino)ethyl fragment of compound 7 was cleaved off and compound 8 was formed. The constitutions of the novel compounds were confirmed based on spectral data. The antibacterial activity was evaluated for the prepared compounds against two gram-negative and two gram-positive bacteria. Among them, compound 12b (inhibition zone 16 ± 0.7 mm) was the most promising against S. aureus compared to Gentamycin (15 ± 0 mm). Also, compounds 5a and 5d exerted comparable antibacterial activity (inhibition zones 13 ± 1.4 and 13 ± 2.1 mm), respectively to Gentamycin against S. aureus. Minimum inhibitory concentration (MIC) evaluation against S. aureus showed that compound 12b had the lowest MIC value (78.1 µg/mL).
Supplementary Information
The online version contains supplementary material available at 10.1186/s13065-025-01421-5.
Keywords: Ring annelation; 1-(1H-benzo[d]imidazol-2-yl)guanidine; 1,3,4a,9-tetraza-4H-fluoren-2-amines; phenoxy-N-arylacetamide; Trans esterification; Antibacterial activity
Introduction
Benzimidazoles are the fundamental component of a wide range of biochemical and medicinal substances with varying chemical and pharmacological properties. Numerous derivatives of benzimidazoles have a variety of biological characteristics, including antitumor [1–6], antifungal [7, 8], antiviral [9–11], antihistaminic [12–14] antibacterial [15, 16], and anticonvulsant activity [17, 18]. Representative examples of drugs containing benzimidazole moiety are depicted in Fig. 1 (compounds I [19–21], II [22–24], III [25–27]).
Fig. 1.
Some drugs containing benzimidazole or [1,3,5]triazine cores
Moreover, triazines are benzene-like six-membered planar structures having three nitrogen atoms [28]. The triazine scaffold is the most well-known heterocycle, with a wide spectrum of biological activity [28–31]. There are three triazine isomers, namely, 1,2,4-triazine, 1,2,3-triazine, and 1,3,5-triazine. 1,3,5-Triazine is the most studied due to its distinct chemical structure and medicinal capabilities [30, 31]. For example, 1,3,5-triazine-thiazolidine-dione IV [30] has been reported as a DPP-4 inhibitor with antibacterial activity targeting the S1 pocket for the treatment of type 2 diabetes [30] (Fig. 1). Also, triazine dimer V [31] has been reported as an antileishmanial agent (Fig. 1) [31].
Besides, it was noted that compounds with acetamide linkages as core structures have drawn a lot of interest because of their possible therapeutic applications, including anticancer [32, 33], haemolytic [34], antioxidant [35], antitubercular [36], antiurease [34], antimicrobial [34, 37, 38], anti-inflammatory [39], anticonvulsant [40], analgesic [38, 39], anti-COVID-19 [41], and antituberculosis [42].
Moreover, pyrazoles, a five-membered heterocycle with two neighboring nitrogen atoms, are the fundamental structures found in a variety of compounds with diverse biological activities such as anticancer [43, 44], anti-inflammatory [45, 46], antimicrobial [46, 47], antioxidant [48, 49], and anticonvulsant [50] activities. Furthermore, bis-heterocycles, which consist of two bioactive heterocycles linked by a flexible linker, have been reported to possess plant growth regulative, anticancer, antibacterial, and fungicidal properties [51–55]. They can also be used as chelating agents, electrical conducting compounds [56], and metal ligands [57].
Fluorene is one example of a polyaromatic hydrocarbon (PAH), an essential precursor used in manufacturing as a component of plastics, insecticides, resins, dyes, and medications [58–60]. It was found that replacing one or more carbon atoms with heteroatoms results in significant alterations of its biological activity [61, 62]. Thus, in continuation of our interest in the synthesis of bioactive heterocycles [63–87], we aim to prepare hybrid heterocycles based on 1,3,4a,9-tetraza-4H-fluoren-2-amines tethered phenoxy-N-arylacetamide, and pyrazole moiety.
Results and discussion
According to the preceding general procedure, the reaction of o-phenylenediamine 1 with cyanoguanidine 2 in a refluxing water-HCl mixture produces 1-(1H-benzo[d]imidazol-2-yl)guanidine 3 (Scheme 1).
Scheme 1.
Synthesis of 1-(1H-benzo[d]imidazol-2-yl)guanidine 3
The reaction of 1-(1H-benzo[d]imidazol-2-yl)guanidine 3 with 2-(4-formylphenoxy)-N-arylacetamides 4a-d in ethanol in the presence of piperidine as a basic catalyst leads to the formation of 2-(4-(2-amino-3,4-dihydrobenzo[4,5]imidazo[1,2-a][1,3,5]triazin-4-yl)phenoxy)-N-phenylacetamides 5a-d in which the benzo[4,5]imidazo[1,2-a][1,3,5]triazine moiety is linked to phenoxy-N-arylacetamide moieties (Scheme 2).
Scheme 2.
Synthesis of 2-(4-(dihydrobenzo[4,5]imidazo[1,2-a][1,3,5]triazin-4-yl)phenoxy)-N-arylacetamides 5a-d
The constitution of the formed products was proved based on spectral data. For example, the mass spectrum of 5a revealed a molecular ion peak at m/z 412. The IR spectrum of compound 5a showed characteristic N-H stretching bands at
3449 and 3325 cm− 1 and a strong absorption band at
1674 cm− 1 for the carbonyl group. The 1H NMR spectrum displayed a singlet at δ 4.69 ppm for OCH2 protons besides a multiplet at δ 6.68–7.62 ppm integrated for 14 protons corresponding to the aromatic protons and H-4. It also demonstrated three singlet signals (exchangeable with D2O) at δ 6.39 (2 H), 7.98 (1H), and 10.06 (1H) ppm assigned to NH2 and 2 NH protons. In addition, the 13C NMR showed peaks at δ 65.6 and 67.1 ppm for aliphatic carbons OCH2 and C-4 as well as a characteristic peak at δ 166.4 for the amide group. Peaks of the aromatic carbons appear at their appropriate position.
Compounds 5 can be seen as 1,3,4a,9-tetraza-4H-fluoren-2-amines, as illustrated in Fig. 2. It has been observed that replacing one or more carbon atoms of a carbocyclic molecule with heteroatoms results in significant alterations of its biological activity [88–91].
Fig. 2.
Structures of 9H-fluorene and1,3,4a,9-tetraza-4H-fluoren-2-amines 5
However, the formed dihydrobenzo[4,5]imidazo[1,2-a][1,3,5]triazine could exist in three tautomeric structures, namely 3,4-dihydro- 5, 1,4-dihydro- 5(I), and 4,10-dihydro- 5(II) tautomeric forms, the 3,4-dihydro- isomer is predominant in the crystal form, as indicated in related work [92] (Fig. 3).
Fig. 3.
Isomeric structures of [4,5]imidazo[1,2-a][1,3,5]triazines 5
On the other hand, trials to prepare the benzo[4,5]imidazo[1,2-a][1,3,5]triazines 7 which are linked to benzoyloxyacetamide via the direct reaction of 3 with 2-oxo-2-(phenylamino)ethyl 4-formylbenzoate derivatives 6a-d under the same condition of absolute ethanol at reflux in presence of a catalytic amount of piperidine did not succeed. Instead, in all these examples, only ethyl 4-(2-amino-3,4-dihydrobenzo[4,5]imidazo[1,2-a][1,3,5]triazin-4-yl)benzoate 8 was obtained as the sole product (Scheme 3).
Scheme 3.
Synthesis of ethyl 4-(2-amino-3,4-dihydrobenzo[4,5]imidazo[1,2-a][1,3,5]triazin-4-yl)benzoate 8
Compound 8 was formed due to the transesterification of the initially formed 7a-d as indicated in the following mechanism. The nucleophilic attack of ethanol to the carbonyl ester of 7 leads to the tetrahedral intermediate 9 that was deprotonated in the presence of a basic catalyst (piperidine) into the intermediate 10 that affords the final isolable product 8 (Scheme 4).
Scheme 4.
Unexpected formation of ethyl 4-(2-amino-3,4-dihydrobenzo[4,5]imidazo[1,2-a][1,3,5]triazin-4-yl)benzoate 8
The chemical constitution of compound 8 was undoubtedly confirmed by the aid of spectral tools and elemental analysis. The mass spectrum showed a molecular ion peak at m/z 335, consistent with the proposed structure. The IR spectrum revealed the presence of a characteristic absorption band at
1713 cm− 1 for the ester carbonyl stretch, and broad absorption bands at
3418 and 3248 cm− 1 for NH2 and NH group. The 1H NMR further confirmed the transesterification as it showed the absence of any peaks for OCH2 and amide NH protons. Instead, ethoxy protons appeared as a characteristic triplet and quartet at δ 1.26 and 4.25 ppm (pJ = 7.2 Hz). NH2 and NH protons gave peaks at δ 6.42 (2 H) and 8.09 (1H) ppm, respectively. Other peaks for aromatic protons and H-4 exist in their expected position. 13C NMR spectrum showed peaks for carbons of ethoxy group at δ 14.2 and 61.1 ppm. It revealed also peaks at δ 65.4 ppm for C-4, and at δ 165.3 ppm for ester carbonyl. Peaks of other aromatic carbons appeared as expected.
To achieve the concept of molecular hybridization, we attempt to introduce the biologically active pyrazole ring into the structure of 1,3,4a,9-tetraza-4H-fluoren-2-amines (benzo[4,5]imidazo[1,2-a][1,3,5]triazines). For this purpose, 1-phenyl-3-aryl-1H-pyrazole-4-carbaldehydes 11a-c were chosen as starting materials and were allowed to react with 3 in ethanol at reflux in the presence of a few drops of piperazine. Interestingly, benzo[4,5]imidazo[1,2-a][1,3,5]triazines 12a-c which are linked to a pyrazole moiety at position-4 has been generated in good yields (Scheme 5).
Scheme 5.
Synthesis of pyrazole-containing 1,3,4a,9-tetraza-4H-fluoren-2-amines 12a-c
The chemical composition of the products was verified by the different spectral tools. For example, the mass spectrum of 12b (Ar = 4-MeC6H4) demonstrated a molecular ion peak at m/z 419 which fits with the proposed structure. The IR spectrum of compound 12 showed absorption bands at
3546 and 3325 cm− 1 for NH2 and NH stretching vibration. The 1H NMR indicated the presence of a signal at δ 2.24 ppm for methyl protons, a doublet at δ 6.57 ppm for H-4, a characteristic signal at δ 9.03 ppm for pyrazole-H5, and two singlet signals at δ 7.04 (2 H), 9.48 (1H) ppm for NH2 and NH, respectively. Signals for the aromatic protons appear at their appropriate position. The 13C NMR spectrum showed characteristic peaks at δ 20.9 and 59.9 ppm for methyl and C-4, respectively. Peaks for other carbons appear in their expected position.
Stimulated by the previously mentioned results, we broadened the scope of this reaction to include the synthesis of 1,3,4a,9-tetraza-4H-fluoren-2-amines 14a-d that are linked to 2-(4-(1-phenyl-1H-pyrazol-3-yl)phenoxy)-N-arylacetamide moieties at position-4 in good yields by the direct reaction of the appropriate 2-(4-(4-formyl-1-phenyl-1H-pyrazol-3-yl)phenoxy)-N-arylacetamides 13a-d with the corresponding mole equivalent of 3 (Scheme 6).
Scheme 6.
Synthesis of 1,3,4a,9-tetraza-4H-fluoren-2-amines 14a-d that are linked to 2-(4-(1-phenyl-1H-pyrazol-3-yl)phenoxy)-N-arylacetamide moieties
The chemical structure of the resulting compounds 14a-d was confirmed based on spectral analyses. For instance, the mass spectrum of 14a indicated a molecular-ion peak at m/z 554 which is relative to the proposed structure. The IR spectrum showed characteristic absorption bands at
3549, 3325, 1674 cm− 1 for NH2, NH, and amide C = O, respectively. The 1H NMR spectrum displayed two characteristic singlets at δ 4.79 and 9.08 ppm for OCH2 and pyrazole-H5, respectively. It showed further multiplets at δ 6.93–7.99 ppm integrated for 21 protons for the amino group, H-4, and aromatic protons, as well as two D2O-exchangeable singlets at δ 8.67 and 10.12 ppm for the two NH groups. The 13C NMR spectrum shows peaks at δ 67.1 and 166.5 ppm for OCH2 and amide C = O. Other peaks are present in close agreement with the proposed structure.
Antibacterial activity
Agar well diffusion assay was used to assess the antibacterial activity of all the prepared compounds against Staphylococcus aureus (S. aureus) and Bacillus subtilis (B. subtilis) (gram-positive bacteria), Escherichia coli (E. coli) and Pseudomonas aeruginosa (P. aeruginosa) (gram-negative bacteria). The results showed that compounds 5a, 5d, and 12b were promising against S. aureus with the inhibition zones of 13 ± 1.4, 13 ± 2.1, and 16 ± 0.7 mm, respectively, and the most effective one was compound 12b compared to Gentamycin (15 ± 0 mm) (Table 1). Concerning B. subtilis, compounds 5a, 5d, 12a, and 12b showed moderate activity with the inhibition zones of 14 ± 0, 16 ± 0.7, 14 ± 0, and 14 ± 1.4 mm, respectively, compared to Gentamycin (20 ± 1.4). Compound 5d had the strongest action against P. aeruginosa (16 ± 0.7 mm), compared to Gentamycin (21 ± 0 mm). Compounds 5a, 5c, and 12b had moderate activity, whereas compound 14d had the lowest activity (10 ± 0 mm) against P. aeruginosa compared to Gentamycin. All the synthesized compounds had no action against E. coli. So, the most promising results were shown against S. aureus compared to Gentamycin. Therefore, S.aureus strain was chosen for further MIC evaluation. Tables 2 and 3; Fig. 4 showed the results of MIC determination. It was found that compound 12b had the lowest MIC value (78.1 µg/mL).
Table 1.
Antibacterial activity of the synthesized compounds at a concentration of 10 mg/mL. The data was mean ± standard deviation (SD) of two separate experiments performed in triplicats
| Inhibition zone diameter (mm) ± SD at 10 mg/mL | ||||
|---|---|---|---|---|
| Sample | S. aureus | B. subtilis | E. coli | P. aeruginosa |
| 5a | 13 ± 1.4 | 14 ± 0 | NA | 14 ± 0 |
| 5b | NA | NA | NA | NA |
| 5c | 12 ± 0 | NA | NA | 13 ± 1.4 |
| 5d | 13 ± 2.1 | 16 ± 0.7 | NA | 16 ± 0.7 |
| 8 | 10 ± 0 | NA | NA | NA |
| 12a | NA | 14 ± 0 | NA | NA |
| 12b | 16 ± 0.7 | 14 ± 1.4 | NA | 14 ± 1.4 |
| 12c | NA | NA | NA | NA |
| 14a | NA | NA | NA | NA |
| 14b | NA | NA | NA | NA |
| 14c | NA | NA | NA | NA |
| 14d | NA | NA | NA | 10 ± 0 |
| Gentamycin | 15 ± 0 | 20 ± 1.4 | 20 ± 2.1 | 21 ± 0 |
| 5% DMSO | 0.0 | 0.0 | 0.0 | 0.0 |
(Gentamycin, 10 µg/disc) was positive control for gram-positive and gram-negative bacteria. *NA: No activity
Table 2.
The effect of different concentrations (10-0.0195 mg/mL) of 5a, 5c, 5d, 8, and 12b on S. Aureus. The data was the mean of duplicate results ± standard deviation (SD)
| Concentration (mg/mL) | S. aureus (Inhibition zone (mm) ± SD) | ||||
|---|---|---|---|---|---|
| 5a | 5c | 5d | 8 | 12b | |
| 10 | 14 ± 1.4 | 12 ± 0 | 12.5 ± 2.1 | 10 ± 0 | 15.5 ± 0.7 |
| 5 | 13 ± 0.7 | 11 ± 0 | 10 ± 0.7 | 10 ± 0 | 14 ± 0 |
| 2.5 | 12 ± 0 | 11 ± 0 | 10 ± 0 | 9 ± 0.7 | 13 ± 1 |
| 1.25 | 11 ± 0 | 10 ± 0.7 | 9 ± 0 | 9 ± 0.7 | 13 ± 0 |
| 0.625 | 0 | 9 ± 0 | 0 | 0 | 12 ± 1 |
| 0.3125 | 0 | 0 | 0 | 0 | 12 ± 0.8 |
| 0.1563 | 0 | 0 | 0 | 0 | 11.5 ± 0 |
| 0.0781 | 0 | 0 | 0 | 0 | 11 ± 0 |
| 0.0391 | 0 | 0 | 0 | 0 | 0 |
| 0.0195 | 0 | 0 | 0 | 0 | 0 |
Table 3.
Minimum inhibitory concentration (MIC) of compounds 5a, 5c, 5d, 8, and 12b against S. Aureus
| Compound | S. aureus |
|---|---|
| MIC (µg/mL) | |
| 5a | 1250 |
| 5c | 625 |
| 5d | 1250 |
| 8 | 1250 |
| 12b | 78.1 |
Fig. 4.
Agar well diffusion assay for estimating the MIC of compounds 5a, 5c, 5d, 8 and 12b against S. aureus. The range of serial dilution concentrations was 1 = 10 mg/mL to 10 = 0.0195 mg/mL. CN10 means Gentamycin positive control
Structure-activity relationship
Figure 5 shows a design for the prepared series of benzo[4,5]imidazo[1,2-a][1,3,5]triazines 5,12, and 14.
Fig. 5.
A general structure of the prepared benzo[4,5]imidazo[1,2-a][1,3,5]triazines 5,12, and 14
The structure-activity relationship demonstrated that the derivatives 5a-d and 12a-c performed better than the derivatives 14a-d. Compound 5d, which included a 4-methoxyphenyl group (an electron-donating group), had the highest antibacterial activity against S. aureus,P. aeuroginosa, and B. subtilis among the 5a-d derivatives. Compound 5a, which included an unsubstituted phenyl group, had a moderate action against S. aureus,P. aeruginosa and B. subtilis. The p-tolyl group (electron-donating group) in derivative 5c demonstrated modest antibacterial activity against S. aureus and P. aeruginosa. On the other hand, derivative 5b with 4-chlorophenyl moiety (electron-withdrawing group) reduced antibacterial efficacy against the tested bacterial strains. The unsubstituted phenyl group in 12a demonstrated moderate activity against B. subtilis, whereas derivative 12b with p-tolyl group exhibited promising action against S. aureus and moderate activity against B. subtilis and P. aeruginosa, respectively. Compound 12c, on the other hand, had decreased activity against all the strains tested. Among compounds 14a-d, only 14d containing a 4-methoxyphenyl group was effective. It showed limited efficacy against P. aeruginosa.
Conclusion
We have described an effective method for creating novel annelated 1,3,4a,9-tetraza-4H-fluoren-2-amines ring systems incorporating phenoxy-N-arylacetamide, and pyrazole moieties. The reaction involves reacting one-mole equivalent of 1-(1H-benzo[d]imidazol-2-yl)guanidine with one-mole equivalent of the appropriate aldehydes. We concluded that compound 5d’s promising action against S. aureus and P. aeruginosa, as well as its modest activity against B. subtilis, might be attributed to its inhibition of the MurG enzyme, as indicated by our molecular docking studies. Furthermore, the promising efficacy of compounds 5a and 5c against S. aureus might be attributed to their inhibitory action on bacterial tyrosyl tRNA synthetase and MurG.
Supplementary file
Compounds 5a is represented here as a representative example. Full experimental details of all compounds and spectral data are represented in the supplementary file.
“Experimental
“Melting points were measured with using a Stuart melting point apparatus and were uncorrected. The IR spectra were recorded using Vector 22 FTIR-spectrophotometer (Brucker, Germany) as KBr pellets. The 1H and 13C NMR spectra were recorded in DMSO-d6 as a solvent with Mercury VXR-300 NMR spectrometer (Varian, USA) operating at 300 MHz and 75 MHz, using TMS as an internal standard. Chemical shifts were reported as δ values in ppm. Mass spectra were recorded with GCMS-QP-1000 EX mass spectrometer (Shimadzu, Japan) in EI (70 eV) model. The elemental analyses were performed using CHNS-932 Vario elemental analyzer (LECO, USA) at the Micro Analytical Centre, Cairo University”.
General method for the synthesis of compounds 5a-d, 8, 12a-c and 14a-d
“A solution of 1-(1H-benzo[d]imidazol-2-yl)guanidine (3) (175 mg, 1 mmol) and the appropriate aldehyde (4a-d), (6a-d), (11a-c), or (13a-d) (1 mmol) in ethanol (10 mL) containing piperidine (2 drops) was heated at reflux for 3 h. The reaction mixture is allowed to cool to ambient temperature. A precipitate is formed which is subsequently filtered, washed with ethanol, and recrystallized from EtOH\dioxane (3:1, v/v) mixture to give the titled compound”.
2-(4-(2-Amino-3,4-dihydrobenzo[4,5]imidazo[1,2-a][1,3,5]triazin-4-yl)phenoxy)-N-phenylacetamide (5a)
Colorless powder (350 mg, 85%); Mp 235–237 ºC; IR (KBr):
3449 (NH2), 3325 (2NH), 1674 (C = O), 1605 (C = N), 1520 (C = C) cm− 1; 1H NMR (300 MHz, DMSO-d6) δ 4.69 (s, 2 H, OCH2), 6.39 (s, 2 H, NH2, D2O exchangeable), 6.70 (d, J = 6.9 Hz, 2 H, Ar-H), 6.78 (t, J = 7.5 Hz, 1H, Ar-H), 6.93 (t, J = 7.5 Hz, 1H, Ar-H), 7.02 (d, J = 8.6 Hz, 2 H, Ar-H), 7.08 (d, J = 8.4 Hz, 1H, H4), 7.22 (d, J = 8.0 Hz, 1H, Ar-H), 7.26–7.36 (m, 4 H, Ar-H), 7.61 (d, J = 8.6 Hz, 2 H), 7.98 (br s, 1H, NH, D2O exchangeable), 10.06 (s, 1H, NH, D2O exchangeable) ppm; 13C NMR (75 MHz, DMSO-d6): δ 65.6, 67.1, 108.4, 115.0, 115.9, 119.0, 119.8, 120.9, 123.7, 127.8, 128.8, 131.2, 133.2, 138.4, 143.1, 153.5, 155.4, 158.4, 166.4 ppm; MS (EI, 70 eV): m/z (%) 412 ]M+[; Anal. Calcd for C23H20N6O2: C, 66.98; H, 4.89; N, 20.38. Found: C, 66.83; H, 4.70; N, 20.18%.
2-(4-(2-Amino-3,4-dihydrobenzo[4,5]imidazo[1,2-a][1,3,5]triazin-4-yl)phenoxy)-N-(4-chlorophenyl)acetamide (5b)
Pale yellow powder (370 mg, 83%); Mp 200–202 ºC; IR (KBr):
3448 (NH2), 3320 (2NH), 1670 (C = O), 1600 (C = N), 1519 (C = C) cm− 1; 1H NMR (300 MHz, DMSO-d6) δ 4.69 (s, 2 H, OCH2), 6.34 (s, 2 H, NH2, D2O exchangeable), 6.69 (d, J = 7.2 Hz, 2 H, Ar-H), 6.76 (t, J = 7.2 Hz, 1H, Ar-H), 6.91 (t, J = 7.5 Hz, 1H, Ar-H), 7.01 (d, J = 8.7 Hz, 2 H, Ar-H), 7.22 (d, J = 7.7 Hz, 1H, H4), 7.32 (d, J = 8.8 Hz, 2 H, Ar-H), 7.36 (d, J = 8.9 Hz, 2 H, Ar-H), 7.65 (d, J = 8.9 Hz, 2 H, Ar-H), 7.92 (s, 1H, NH, D2O exchangeable), 10.20 (s, 1H, NH) ppm; 13C NMR (75 MHz, DMSO-d6) δ 65.9, 67.3, 108.3, 114.6, 116.0, 118.6, 120.1, 120.7, 121.1, 128.1, 129.7, 131.7, 132.6, 133.4, 135.2, 143.4, 154.9, 158.8, 166.6 ppm; MS (EI, 70 eV): m/z (%) 446 ]M+[ Anal. Calcd for C23H19ClN6O2: C, 61.82; H, 4.29; N, 18.81. Found: C, 61.66; H, 4.11; N, 18.64%.
2-(4-(2-Amino-3,4-dihydrobenzo[4,5]imidazo[1,2-a][1,3,5]triazin-4-yl)phenoxy)-N-(p-tolyl)acetamide (5c)
Colorless powder (354 mg, 83%); Mp 204–206 ºC; IR (KBr):
3448 (NH2), 3328 (2NH), 1677 (C = O), 1609 (C = N), 1520 (C = C) cm− 1; 1H NMR (300 MHz, DMSO-d6) δ 2.25 (s, 3 H, CH3), 4.66 (s, 2 H, OCH2), 6.38 (s, 2 H, NH2, D2O exchangeable), 6.69 (d, J = 6.6 Hz, 2 H, Ar-H), 6.76 (t, J = 7.3 Hz, 1H, Ar-H), 6.92 (t, J = 7.1 Hz, 1H, Ar-H), 7.01 (d, J = 8.1 Hz, 2 H, Ar-H), 7.11 (d, J = 7.6 Hz, 2 H, Ar-H), 7.21 (d, J = 7.6 Hz, 1H, H4), 7.33 (d, J = 8.2 Hz, 2 H), 7.49 (d, J = 7.8 Hz, 2 H, Ar-H), 7.96 (br s, 1H, NH, D2O exchangeable), 9.96 (s, 1H, NH, D2O exchangeable) ppm; 13C NMR (75 MHz, DMSO-d6): δ 20.5, 65.5, 67.1, 108.3, 115.0, 115.9, 118.9, 119.9, 120.5, 120.8, 127.7, 129.1, 131.3, 132.7, 133.2, 135.9, 143.4, 155.4, 158.4, 166.1 ppm; MS (EI, 70 eV): m/z (%) 426 ]M+[ Anal. Calcd for C24H22N6O2: C, 67.59; H, 5.20; N, 19.71. Found: C, 67.39; H, 5.02; N, 19.53%.
2-(4-(2-Amino-3,4-dihydrobenzo[4,5]imidazo[1,2-a][1,3,5]triazin-4-yl)phenoxy)-N-(4-methoxyphenyl)acetamide (5d)
Grey powder (380 mg, 86%); Mp 240–242 ºC; IR (KBr):
3448 (NH2), 3330 (2NH), 1678 (C = O), 1608 (C = N), 1522 (C = C) cm− 1; 1H NMR (300 MHz, DMSO-d6) δ 3.72 (s, 3 H, OCH3), 4.65 (s, 2 H, OCH2), 6.37 (s, 2 H, NH2, D2O exchangeable), 6.69 (d, J = 6.2 Hz, 2 H, Ar-H), 6.77 (t, J = 7.5 Hz, 1H, Ar-H), 6.88 (d, J = 8.2 Hz, 2 H, Ar-H), 6.93 (d, J = 7.5 Hz, 1H, Ar-H), 7.02 (d, J = 7.9 Hz, 2 H, Ar-H), 7.21 (d, J = 7.7 Hz, 1H, H4), 7.33 (d, J = 8.1 Hz, 2 H, Ar-H), 7.51 (d, J = 8.7 Hz, 2 H, Ar-H), 7.95 (s, 1H, NH, D2O exchangeable), 9.91 (s, 1H, NH, D2O exchangeable) ppm; 13C NMR (75 MHz, DMSO-d6) δ 58.1, 65.5, 69.1, 108.3, 115.0, 115.5, 116.0, 119.8, 120.1, 120.8, 129.1, 131.7, 132.3, 133.4, 135.9, 144.3, 154.5, 158.4, 160.3, 167.4 ppm; MS (EI, 70 eV): m/z (%) 442 ]M+[ Anal. Calcd for C24H22N6O3: C, 65.15; H, 5.01; N, 18.99. Found: C, 64.97; H, 4.87; N, 18.82%.
Ethyl 4-(2-amino-3,4-dihydrobenzo[4,5]imidazo[1,2-a][1,3,5]triazin-4-yl)benzoate (8)
Wite powder (295 mg, 88%); Mp 208–210 ºC; IR (KBr): h
3418 (NH2), 3248 (NH), 1713 (C = O), 1628 (C = N), 1528 (C = C) cm− 1; 1H NMR (300 MHz, DMSO-d6) δ 1.28 (t, J = 7.2 Hz, 3 H, COOCH2CH3), 4.29 (q, J = 7.2 Hz, 2 H, COOCH2CH3), 6.42 (s, 2 H, NH2, D2O exchangeable), 6.74 (d, J = 7.5 Hz, 1H, H4), 6.79 (t, J = 7.4 Hz, 1H, Ar-H), 6.84 (s, 1H, H4), 6.94 (t, J = 7.4 Hz, 1H, Ar-H), 7.24 (d, J = 7.8 Hz, 1H, Ar-H), 7.48 (d, J = 7.9 Hz, 2 H, Ar-H), 7.96 (d, J = 7.7 Hz, 2 H, Ar-H), 8.09 (s, 1H, NH, D2O exchangeable) ppm; 13C NMR (75 MHz, DMSO-d6): δ 14.2, 61.1, 65.4, 108.5, 116.1, 119.3, 121.4, 126.6, 128.7, 130.0, 130.7, 131.1, 143.2, 145.3, 155.2, 165.3 ppm; MS (EI, 70 eV): m/z (%) 335 ]M+[. Anal. Calcd for C18H17N5O2: C, 64.47; H, 5.11; N, 20.88. Found: C, 64.33; H, 4.95; N, 20.70%.
4-(1,3-Diphenyl-1H-pyrazol-4-yl)-3,4-dihydrobenzo[4,5]imidazo[1,2-a][1,3,5]triazin-2-amine (12a)
Colorless powder (352 mg, 87%); Mp 280–282 ºC; IR (KBr):
3540 (NH2), 3325 (NH), 1604 (C = N), 1520 (C = C) cm− 1; 1H NMR (300 MHz, DMSO-d6) δ 6.40 (d, J = 7.9 Hz, 1H, H4), 6.51(s, 2 H, NH2, D2O exchangeable), 6.69 (t, J = 7.6 Hz, 1H, Ar-H), 6.88 (d, J = 7.2 Hz, 2 H, Ar-H), 7.15 (d, J = 7.8 Hz, 1H, Ar-H), 7.33 (t, J = 7.4 Hz, 1H, Ar-H), 7.41 (d, J = 6.6 Hz, 2 H, Ar-H), 7.50 (t, J = 7.7 Hz, 3 H, Ar-H), 7.65 (d, J = 7.6 Hz, 2 H, Ar-H), 7.90 (d, J = 8.0 Hz, 2 H, Ar-H), 8.25 (br s, 1H, NH, D2O exchangeable), 8.76 (s, 1H, pyrazole-H5) ppm; 13C NMR (75 MHz, DMSO-d6): δ 62.6, 111.2, 118.1, 118.5, 119.2, 122.9, 123.8, 127.0, 128.0, 128.2, 128.9, 129.2, 129.4, 129.6, 130.2, 137.6, 139.5, 150.5, 151.4, 157.7 ppm; MS (EI, 70 eV): m/z (%) 405 ]M+[ Anal. Calcd for C24H19N7: C, 71.09; H, 4.72; N, 24.18. Found: C, 70.96; H, 4.56; N, 24.04%.
4-(1-Phenyl-3-(p-tolyl)-1H-pyrazol-4-yl)-3,4-dihydrobenzo[4,5]imidazo[1,2-a][1,3,5]triazin-2-amine (12b)
Wite powder (369 mg, 88%); Mp 295–297 ºC; IR (KBr): h
3546 (NH2), 3325 (NH), 1604 (C = N), 1525 (C = C) cm− 1; 1H NMR (300 MHz, DMSO-d6) δ 2.34 (s, 3 H, CH3), 6.58 (d, J = 7.9 Hz, 1H, H4), 7.04 (s, 2 H, NH2, D2O exchangeable), 7.17 (d, J = 7.8 Hz, 1H, Ar-H), 7.23 (d, J = 7.6 Hz, 2 H, Ar-H), 7.33 (d, J = 7.9 Hz, 3 H, Ar-H), 7.43 (d, J = 8.0 Hz, 2 H, Ar-H), 7.52 (t, J = 7.7 Hz, 3 H, Ar-H), 7.89 (d, J = 8.2 Hz, 2 H, Ar-H), 9.03 (s, 1H, pyrazole-H5), 9.48 (br s, 1H, NH, D2O exchangeable) ppm; 13C NMR (75 MHz, DMSO-d6): δ 20.9, 59.9, 110.2, 111.7, 118.5, 119.2, 122.9, 123.8, 127.0, 128.0, 128.2, 128.9, 129.2, 129.4, 129.7, 130.1, 138.2, 139.0, 150.8, 151.2, 156.7 ppm; MS (EI, 70 eV): m/z (%) 419 ]M+[ Anal. Calcd for C25H21N7: C, 71.58; H, 5.05; N, 23.37. Found: C, 71.43; H, 4.95; N, 23.18%.
4-(3-(4-Methoxyphenyl)-1-phenyl-1H-pyrazol-4-yl)-3,4-dihydrobenzo[4,5]imidazo[1,2-a][1,3,5]triazin-2-amine (12c)
Colorless powder (374 mg, 86%); Mp 287–289 ºC; IR (KBr):
3549 (NH2), 3325 (NH), 1674 (C = O), 1605 (C = N), 1528 (C = C) cm− 1; 1H NMR (300 MHz, DMSO-d6) δ 3.78 (s, 3 H, OCH3), 6.50 (d, J = 7.6 Hz, 1H, H4), 6.92 (s, 2 H, NH2, D2O exchangeable), 6.97 (d, J = 8.3 Hz, 2 H, Ar-H), 7.07 (d, J = 7.5 Hz, 1H, Ar-H), 7.13 (s, 2 H, Ar-H), 7.27 (d, J = 7.8 Hz, 1H, Ar-H), 7.35 (d, J = 8.1 Hz, 1H, Ar-H), 7.50 (d, J = 6.1 Hz, 4 H, Ar-H), 7.88 (d, J = 8.1 Hz, 2 H, Ar-H), 8.37 (s, 1H, NH, D2O exchangeable), 8.87 (s, 1H, pyrazole-H5) ppm; 13C NMR (75 MHz, DMSO-d6): δ 55.4, 61.8, 110.5, 111.9, 118.4, 119.2, 122.9, 123.8, 127.2, 128.16, 128.18, 128.9, 129.3, 129.4, 129.7, 138.0, 138.6, 150.6, 151.2, 156.7, 159.4 ppm; MS (EI, 70 eV): m/z (%) 435 ]M+[ Anal. Calcd for C25H21N7O: C, 68.95; H, 4.86; N, 22.51. Found: C, 68.79; H, 4.69; N, 22.39%.
2-(4-(4-(2-Amino-3,4-dihydrobenzo[4,5]imidazo[1,2-a][1,3,5]triazin-4-yl)-1-phenyl-1H-pyrazol-3-yl)phenoxy)-N-phenylacetamide (14a)
White powder (415 mg, 75%); Mp 240–242 ºC; IR (KBr):
3549 (NH2), 3325 (NH), 1674 (C = O), 1605 (C = N), 1528 (C = C) cm− 1; 1H NMR (300 MHz, DMSO-d6): δ 4.79 (s, 2 H, OCH2), 6.92 (s, 1H, H4), 7.09–7.18 (m, 3 H, NH2, Ar-H), 7.35 (s, 4 H, Ar-H), 7.54 (s, 4 H, Ar-H), 7.67 (d, J = 18.5 Hz, 5 H, Ar-H), 7.99 (s, 4 H, Ar-H), 8.67 (s, 1H, NH, D2O exchangeable), 9.08 (s, 1H, pyrazole-H5), 10.12 (s, 1H, NH, D2O exchangeable) ppm; 13C NMR (75 MHz, DMSO-d6): δ 67.2, 71.5, 110.5, 115.1, 115.7, 116.3, 119.0, 119.8, 120.6, 122.5, 123.9, 124.9, 127.3, 128.6, 128.9, 129.8, 130.0, 130.3, 138.4, 139.0, 142.8, 152.7, 153.6, 158.4, 160.2, 166.5.ppm; MS (EI, 70 eV): m/z (%) 554 ]M+[ Anal. Calcd for C32H26N8O2: C, 69.30; H, 4.73; N, 20.20. Found: C, 69.12; H, 4.57; N, 20.01%.
2-(4-(4-(2-Amino-3,4-dihydrobenzo[4,5]imidazo[1,2-a][1,3,5]triazin-4-yl)-1-phenyl-1H-pyrazol-3-yl)phenoxy)-N-(4-chlorophenyl)acetamide (14b)
Yellow powder (430 mg, 73%); Mp 180–182 ºC; IR (KBr):
3549 (NH2), 3325 (NH), 1670 (C = O), 1604 (C = N), 1525 (C = C) cm− 1; 1H NMR (300 MHz, DMSO-d6): δ 4.79 (s, 2 H, OCH2), 6.59 (d, J = 8.8 Hz, 1H, H4), 7.12 (t, J = 8.9 Hz, 3 H, NH2, Ar-H), 7.39 (td, J = 12.3, 8.3 Hz, 5 H, Ar-H), 7.55 (d, J = 7.9 Hz, 2 H, Ar-H), 7.58–7.66 (m, 2 H, Ar-H), 7.69 (d, J = 8.8 Hz, 2 H, Ar-H), 7.95 (dd, J = 12.7, 8.6 Hz, 5 H, Ar-H), 9.27 (s, 1H, pyrazole-H5), 9.97 (s, 1H, NH, D2O exchangeable), 10.28 (s, 1H, NH, D2O exchangeable) ppm; 13C NMR (75 MHz, DMSO-d6): δ 66.9, 70.7, 108.9, 114.86, 114.93, 115.4, 115.9, 118.3, 118.9, 119.2, 119.9, 121.1, 125.0, 126.6, 129.1, 129.4, 129.5, 130.3, 131.1, 133.5, 135.8, 138.6, 143.3, 150.3, 158.1, 166.3 ppm;.MS (EI, 70 eV): m/z (%) 589 ]M+[ Anal. Calcd for C32H25ClN8O2: C, 65.25; H, 4.28; N, 19.02. Found: C, 65.05; H, 4.15; N, 18.86%.
2-(4-(4-(2-Amino-3,4-dihydrobenzo[4,5]imidazo[1,2-a][1,3,5]triazin-4-yl)-1-phenyl-1H-pyrazol-3-yl)phenoxy)-N-(p-tolyl)acetamide (14c)
Colorless powder (454 mg, 80%); Mp 193–195 ºC; IR (KBr):
3549 (NH2), 3325 (NH), 1672 (C = O), 1604 (C = N), 1527 (C = C) cm− 1; 1H NMR (300 MHz, DMSO-d6) δ 2.26 (s, 3 H, CH3), 4.72 (s, 2 H, OCH2), 6.29 (s, 2 H, NH2, D2O exchangeable), 6.41 (d, J = 7.8 Hz, 1H, H4), 6.79–6.92 (m, 3 H, Ar-H), 7.06–7.20 (m, 5 H, Ar-H), 7.30–7.35 (m, 1H, Ar-H), 7.46–7.55 (m, 5 H, Ar-H), 7.64 (d, J = 7.2 Hz, 1H, Ar-H), 7.90 (d, J = 9.1 Hz, 2 H, Ar-H), 8.70 (s, 1H, NH, D2O exchangeable), 9.15 (s, 1H, pyrazole-H5), 10.02 (s, 1H, NH, D2O exchangeable) ppm; 13C NMR (75 MHz, DMSO-d6): δ 20.5, 67.2, 70.7, 108.4, 114.8, 114.9, 115.9, 118.3, 119.0, 119.2, 119.8, 120.8, 125.2, 126.6, 129.1, 129.5, 129.6, 129.7, 130.1, 131.5, 132.7, 135.8, 139.1, 143.3, 150.4, 158.0, 166.1 ppm; MS (EI, 70 eV): m/z (%) 568 ]M+[ Anal. Calcd for C33H28N8O2: C, 69.70; H, 4.96; N, 19.71. Found: C, 69.59; H, 4.81; N, 19.58%.
2-(4-(4-(2-Amino-3,4-dihydrobenzo[4,5]imidazo[1,2-a][1,3,5]triazin-4-yl)-1-phenyl-1H-pyrazol-3-yl)phenoxy)-N-(4-methoxyphenyl)acetamide (14d)
Grey powder (450 mg, 77%); Mp 182–184 ºC; IR (KBr):
3549 (NH2), 3325 (NH), 1674 (C = O), 1605 (C = N), 1528 (C = C) cm− 1; 1H NMR (300 MHz, DMSO-d6) δ 3.72 (s, 3 H, OCH3), 4.70 (s, 2 H, OCH2), 6.30 (s, 2 H, NH2, D2O exchangeable), 6.41 (d, J = 7.3 Hz, 1H, H4), 6.70 (d, J = 7.6 Hz, 1H, Ar-H), 6.88 (t, J = 4.5 Hz, 4 H, Ar-H), 7.04–7.11 (m, 2 H, Ar-H), 7.44–7.68 (m, 8 H, Ar-H), 7.89 (d, J = 8.2 Hz, 2 H, Ar-H), 8.70 (s, 1H, NH, D2O exchangeable), 9.28 (s, 1H, pyrazole-H5), 9.95 (s, 1H, NH, D2O exchangeable) ppm; MS (EI, 70 eV): m/z (%) 584 ]M+[ Anal. Calcd for C33H28N8O3: C, 67.80; H, 4.83; N, 19.17. Found: C, 67.61; H, 4.67; N, 18.99%.
Antibacterial assay
The antibacterial activity of the prepared compounds was assessed by using the agar well diffusion assay. The antibacterial activity was screened against two gram-positive bacteria Staphylococcus aureus (ATCC 6538) and Bacillus subtilis (DSM 1088) as well as two gram-negative bacteria Pseudomonas aeruginosa (ATCC 10145) and Escherichia coli (ATCC 8739). Dimethyl sulfoxide (DMSO) was used to make a solution of 10 mg/mL of each synthesized compound. The nutrient agar medium was poured on the plates and let to be cooled to 45 °C. 105-106 colony forming unit (CFU) per mL from an overnight bacterial culture was cultured on nutrient agar plates. Then, 6 mm wells were created in the nutritional medium using sterile metallic bores. After that, 20 µL of each tested compound (10 mg/mL) was added to the prepared well. Herein, the negative control was 5% DMSO and the results were compared to standard Gentamycin (10 µg/disc) and Clindamycin (2 µg/disc) (positive controls). The inhibition zone diameter in (mm) was measured using a calliper after the incubation of the plates at 37 °C for (18–24) hours. The experiment was repeated twice and in each time was done in triplicates. The minimum inhibition concentration (MIC) of compounds 5a, 5c, 5d, 8 and 12b was determined against S. aureus. A serial dilution method with concentrations ranging from 10 to 0.0195 mg/mL was utilized. The MIC is the lowest concentration of the target drug that can inhibit the growth of the studied bacteria.
Electronic supplementary material
Below is the link to the electronic supplementary material.
Acknowledgements
This paper is based upon work supported by the Science, Technology, and Innovation Funding Authority (STDF) under grant 48572.
Author contributions
R.E.A. suggested the research plan, carried out the laboratory work, participated in data analysis, shared in writing the original draft of the manuscript, and followed up the experimental work. A.H.M.E., A.M.A., and I.A.A. suggested the research plan, and shared in writing the original draft of the manuscript. N.S.I carried out the biological activity work, participated in data analysis, and shared in writing the original draft of the manuscript. All authors gave final approval for publication.
Funding
Open access funding provided by The Science, Technology & Innovation Funding Authority (STDF) in cooperation with The Egyptian Knowledge Bank (EKB).
This paper is based upon work supported by Science, Technology & Innovation Funding Authority (STDF) under grant 48572.
Data availability
All data generated or analyzed during this study are included in this published article and its supplementary information file. Data available at request (Ismail A. Abdelhamid, ismail_shafy@yahoo.com, ismail_shafy@cu.edu.eg).
Declarations
Ethics approval and consent to participate
Not applicable.
Consent for publication
Not applicable.
Competing interests
The authors declare no competing interests.
Footnotes
Publisher’s note
Springer Nature remains neutral with regard to jurisdictional claims in published maps and institutional affiliations.
Contributor Information
Ahmed H. M. Elwahy, Email: aelwahy@cu.edu.eg, Email: aelwahy@hotmail.com
Ismail A. Abdelhamid, Email: ismail_shafy@yahoo.com, Email: ismail_shafy@cu.edu.eg
References
- 1.Shrivastava N, Naim MJ, Alam MJ, Nawaz F, Ahmed S, Alam O. Benzimidazole Scaffold as Anticancer Agent: synthetic approaches and structure–activity relationship. Arch Pharm (Weinheim). 2017;350:e201700040. 10.1002/ARDP.201700040. [DOI] [PubMed] [Google Scholar]
- 2.Akhtar MJ, Yar MS, Sharma VK, Khan AA, Ali Z, Haider MR, et al. Recent progress of Benzimidazole hybrids for Anticancer potential. Curr Med Chem. 2019;27:5970–6014. [DOI] [PubMed] [Google Scholar]
- 3.Feng LS, Su WQ, Cheng JB, Xiao T, Li HZ, Chen DA, et al. Benzimidazole hybrids as anticancer drugs: an updated review on anticancer properties, structure–activity relationship, and mechanisms of action (2019–2021). Arch Pharm (Weinheim). 2022;355:2200051. 10.1002/ARDP.202200051. [DOI] [PubMed] [Google Scholar]
- 4.Satija G, Sharma B, Madan A, Iqubal A, Shaquiquzzaman M, Akhter M, et al. Benzimidazole based derivatives as anticancer agents: structure activity relationship analysis for various targets. J Heterocycl Chem. 2022;59:22–66. 10.1002/JHET.4355. [Google Scholar]
- 5.Zhou W, Zhang W, Peng Y, Jiang Z-H, Zhang L, Du Z. Design, synthesis and Anti-tumor Activity of Novel Benzimidazole-Chalcone hybrids as non-intercalative topoisomerase II catalytic inhibitors. Molecules. 2020;25. [DOI] [PMC free article] [PubMed]
- 6.Wu L, Yang Y, Wang Z, Wu X, Su F, Li M, et al. Design, synthesis, and biological evaluation of aromatic amide-substituted benzimidazole-derived chalcones. The effect of upregulating TP53 protein expression. Molecules. 2020;25:1162. [DOI] [PMC free article] [PubMed] [Google Scholar]
- 7.Çevik UA, Celik I, Işık A, Pillai RR, Tallei TE, Yadav R, et al. Synthesis, molecular modeling, quantum mechanical calculations and ADME estimation studies of benzimidazole-oxadiazole derivatives as potent antifungal agents. J Mol Struct. 2022;1252:132095. [Google Scholar]
- 8.Güzel E, Acar Çevik U, Evren AE, Bostancı HE, Gül ÜD, Kayış U, et al. Synthesis of Benzimidazole-1,2,4-triazole derivatives as potential antifungal agents targeting 14α-Demethylase. ACS Omega. 2022;8:4369–84. 10.1021/ACSOMEGA.2C07755/SUPPL_FILE/AO2C07755_SI_001.PDF. [DOI] [PMC free article] [PubMed] [Google Scholar]
- 9.Kanwal A, Ahmad M, Aslam S, Naqvi SAR, Saif MJ. Recent advances in antiviral benzimidazole derivatives: a Mini Review. Pharm Chem J. 2019;53:179–87. 10.1007/S11094-019-01976-3/FIGURES/11. [Google Scholar]
- 10.Chen M, Su S, Zhou Q, Tang X, Liu T, Peng F, et al. Antibacterial and antiviral activities and action mechanism of flavonoid derivatives with a benzimidazole moiety. J Saudi Chem Soc. 2021;25:101194. [Google Scholar]
- 11.Marinescu M. Benzimidazole-Triazole hybrids as Antimicrobial and Antiviral agents: a systematic review. Antibiot 2023. Page 1220. 2023;12:12:1220. 10.3390/ANTIBIOTICS12071220. [DOI] [PMC free article] [PubMed] [Google Scholar]
- 12.Wang XJ, Xi MY, Fu JH, Zhang FR, Cheng GF, Yin DL, et al. Synthesis, biological evaluation and SAR studies of benzimidazole derivatives as H1-antihistamine agents. Chin Chem Lett. 2012;23:707–10. [Google Scholar]
- 13.Veerasamy R, Roy A, Karunakaran R, Rajak H. Structure–Activity Relationship Analysis of Benzimidazoles as Emerging Anti-Inflammatory Agents: An Overview. Pharm 2021, Vol 14, Page 663. 2021;14:663. 10.3390/PH14070663 [DOI] [PMC free article] [PubMed]
- 14.Vasava MS, Bhoi MN, Rathwa SK, Jethava DJ, Acharya PT, Patel DB, et al. Benzimidazole: a milestone in the field of Medicinal Chemistry. Mini Rev Med Chem. 2019;20:532–65. [DOI] [PubMed] [Google Scholar]
- 15.Yang X, Syed R, Fang B, Zhou CH. A New Discovery towards Novel Skeleton of Benzimidazole-Conjugated pyrimidinones as Unique Effective Antibacterial agents. Chin J Chem. 2022;40:2642–54. 10.1002/CJOC.202200326. [Google Scholar]
- 16.Ahmed Saleh Alzahrani S, Nazreen S, Elhenawy AA, Neamatallah T, Mahboob M, Synthesis. Biological evaluation, and Molecular Docking of New Benzimidazole-1,2,3-Triazole hybrids as Antibacterial and Antitumor agents. Polycycl Aromat Compd. 2023;43:3380–91. 10.1080/10406638.2022.2069133. [Google Scholar]
- 17.Tiglani D, Salahuddin, Mazumder A, Kumar R, Yar MS, Ahsan MJ, et al. Synthesis anticonvulsant and cytotoxic evaluation of Benzimidazole-Quinoline hybrids Schiff Base Analogs. Polycycl Aromat Compd. 2023. 10.1080/10406638.2023.2183969. [Google Scholar]
- 18.Shabana K, Salahuddin, Mazumder A, Singh H, Kumar R, Tyagi S, et al. Synthesis, characterization, in Silico and in vivo evaluation of Benzimidazole-Bearing Quinoline Schiff Bases as New Anticonvulsant agents. ChemistrySelect. 2023;8:e202300209. 10.1002/SLCT.202300209. [Google Scholar]
- 19.Siwach A, Verma PK. Synthesis and therapeutic potential of imidazole containing compounds. BMC Chem. 2021;15:12. [DOI] [PMC free article] [PubMed] [Google Scholar]
- 20.Garcia-Quiroz J, Camacho J. Astemizole: an old anti-histamine as a New Promising Anti-cancer Drug. Anticancer Agents Med Chem. 2012;11:307–14. [DOI] [PubMed] [Google Scholar]
- 21.Chong CR, Chen X, Shi L, Liu JO, Sullivan DJ. A clinical drug library screen identifies astemizole as an antimalarial agent. Nat Chem Biol 2006 28. 2006;2:415–6. 10.1038/nchembio806. [DOI] [PubMed] [Google Scholar]
- 22.Church MK, Labeaga L. Bilastine: a new H1-antihistamine with an optimal profile for updosing in urticaria. J Eur Acad Dermatology Venereol. 2017;31:1447–52. 10.1111/JDV.14305. [DOI] [PubMed] [Google Scholar]
- 23.Church MK. Safety and efficacy of bilastine: a new H1-antihistamine for the treatment of allergic rhinoconjunctivitis and urticaria. Expert Opin Drug Saf. 2011;10:779–93. 10.1517/14740338.2011.604029. [DOI] [PubMed] [Google Scholar]
- 24.Reddy TP, Dussa N, Mamidi S, Panasa M, Chavakula R, Padma M. Identification and synthesis of potential impurities of bilastine drug substance. Chem Pap. 2022;76:4137–45. 10.1007/S11696-022-02157-5/SCHEMES/5. [Google Scholar]
- 25.Iwamoto K, Uehara Y, Inoue Y, Taguchi K, Muraoka D, Ogo N, et al. Inhibition of STAT3 by Anticancer Drug Bendamustine. PLoS ONE. 2017;12:e0170709. 10.1371/JOURNAL.PONE.0170709. [DOI] [PMC free article] [PubMed] [Google Scholar]
- 26.Lalic H, Aurer I, Batinic D, Visnjic D, Smoljo T, Babic A, Bendamustine. A review of pharmacology, clinical use and immunological effects (review). Oncol Rep. 2022;47:1–16. 10.3892/OR.2022.8325/HTML. [DOI] [PMC free article] [PubMed] [Google Scholar]
- 27.Barman Balfour JA, Goa KL, Bendamustine. Drugs. 2001;61:631–8. 10.2165/00003495-200161050-00009/FIGURES/2. [DOI] [PubMed] [Google Scholar]
- 28.Singla P, Luxami V, Paul K. Triazine as a promising scaffold for its versatile biological behavior. Eur J Med Chem. 2015;102:39–57. [DOI] [PubMed] [Google Scholar]
- 29.Ahmadi F, Mirzaei P, Bazgir A. Cobalt-catalyzed isocyanide insertion cyclization to dihydrobenzoimidazotriazins. Tetrahedron Lett. 2017;58:4281–4. [Google Scholar]
- 30.Srivastava JK, Dubey P, Singh S, Bhat HR, Kumawat MK, Singh UP. Discovery of novel 1,3,5-triazine-thiazolidine-2,4-diones as dipeptidyl peptidase-4 inhibitors with antibacterial activity targeting the S1 pocket for the treatment of type 2 diabetes. RSC Adv. 2015;5:14095–102. 10.1039/C4RA16903D. [Google Scholar]
- 31.Chauhan K, Sharma M, Shivahare R, Debnath U, Gupta S, Prabhakar YS, et al. Discovery of triazine mimetics as potent antileishmanial agents. ACS Med Chem Lett. 2013;4:1108–13. 10.1021/ML400317E/SUPPL_FILE/ML400317E_SI_001.PDF. [DOI] [PMC free article] [PubMed] [Google Scholar]
- 32.Khazir J, Mir BA, Chashoo G, Maqbool T, Riley D, Pilcher L. Design, synthesis, and anticancer evaluation of acetamide and hydrazine analogues of pyrimidine. J Heterocycl Chem. 2020;57:1306–18. [Google Scholar]
- 33.Bhavsar D, Trivedi J, Parekh S, Savant M, Thakrar S, Bavishi A, et al. Synthesis and in vitro anti-HIV activity of N-1,3-benzo[d]thiazol-2-yl-2- (2-oxo-2H-chromen-4-yl)acetamide derivatives using MTT method. Bioorg Med Chem Lett. 2011;21:3443–6. 10.1016/j.bmcl.2011.03.105. [DOI] [PubMed] [Google Scholar]
- 34.Gull Y, Rasool N, Noreen M, Altaf AA, Musharraf SG, Zubair M, et al. Synthesis of N-(6-arylbenzo[d]thiazole-2-acetamide derivatives and their biological activities: an experimental and computational approach. Molecules. 2016;21:1–17. [DOI] [PMC free article] [PubMed] [Google Scholar]
- 35.Ölgen S, Bakar F, Aydin S, Nebioǧlu D, Nebioǧlu S. Synthesis of new indole-2-carboxamide and 3-acetamide derivatives and evaluation their antioxidant properties. J Enzyme Inhib Med Chem. 2013;28:58–64. [DOI] [PubMed] [Google Scholar]
- 36.Ang W, Lin YN, Yang T, Yang JZ, Pi WY, Yang YH, et al. Synthesis and biological evaluation of 2-(3-fluoro-4-nitro phenoxy)-N-phenylacetamide derivatives as novel potential affordable antitubercular agents. Molecules. 2012;17:2248–58. 10.3390/molecules17022248. [DOI] [PMC free article] [PubMed] [Google Scholar]
- 37.Yele V, Azam MA, Wadhwani AD, Synthesis. Molecular Docking and Biological evaluation of 2-Aryloxy-N-Phenylacetamide and N′-(2-Aryloxyoxyacetyl) Benzohydrazide Derivatives as potential Antibacterial agents. Chem Biodivers. 2021;18:e2000907. [DOI] [PubMed] [Google Scholar]
- 38.Mikhailovskii AG, Pogorelova ES, Pershina NN, Makhmudov RR, Novikova VV. Synthesis and analgesic, Antihypoxic, and antimicrobial activity of (Z)-2-(2-Arylhydrazono)-2-(3,3-Dimethyl-3,4-Dihydroisoquinolin-1-Yl)Acetamides. Pharm Chem J. 2020;53:1013–7. [Google Scholar]
- 39.Yusov AS, Chashchina SV, Mikhailovskii AG, Rudakova IP. Synthesis and analgesic and anti-inflammatory activities of (3,3-Dipropyl-6,7-Dimethoxy-3,4-Dihydroisoquinolin-1(2H)-Ylidene)-Acetamide Hydrochlorides. Pharm Chem J. 2019;53:35–9. [Google Scholar]
- 40.Severina HI, Skupa OO, Voloshchuk NI, Georgiyants VA. Synthesis, docking study, and pharmacological evaluation of S-acetamide derivatives of 4,6-dimethyl-2-thiopyrimidine as anticonvulsant agents. J Appl Pharm Sci. 2020;10:1–8. [Google Scholar]
- 41.Mary SJJ, Siddique MUM, Pradhan S, Jayaprakash V, James C. Quantum chemical insight into molecular structure, NBO analysis of the hydrogen-bonded interactions, spectroscopic (FT–IR, FT–Raman), drug likeness and molecular docking of the novel anti COVID-19 molecule 2-[(4,6-diaminopyrimidin-2-yl)sulfanyl]-N-(4-fluo. Spectrochim Acta - Part Mol Biomol Spectrosc. 2021;244:118825. 10.1016/j.saa.2020.118825. [DOI] [PMC free article] [PubMed] [Google Scholar]
- 42.Borsoi AF, Paz JD, Abbadi BL, Macchi FS, Sperotto N, Pissinate K, et al. Design, synthesis, and evaluation of new 2-(quinoline-4-yloxy)acetamide-based antituberculosis agents. Eur J Med Chem. 2020;192:112179. [DOI] [PubMed] [Google Scholar]
- 43.Metwally NH, Badawy MA, Okpy DS. Synthesis and anticancer activity of some new thiopyrano[2,3-d]thiazoles incorporating pyrazole moiety. Chem Pharm Bull. 2015;63:495–503. [DOI] [PubMed] [Google Scholar]
- 44.Alam R, Wahi D, Singh R, Sinha D, Tandon V, Grover A, et al. Design, synthesis, cytotoxicity, HuTopoIIα inhibitory activity and molecular docking studies of pyrazole derivatives as potential anticancer agents. Bioorg Chem. 2016;69:77–90. [DOI] [PubMed] [Google Scholar]
- 45.Farghaly AA, Bekhit AA, Park JY. Design and synthesis of some oxadiazolyl, thiadiazolyl, thiazolidinyl, and thiazolyl derivatives of 1H-pyrazole as anti-inflammatory antimicrobial agents. Arch Pharm (Weinheim). 2000;333:53–7. [DOI] [PubMed]
- 46.Kendre BV, Landge MG, Bhusare SR. Synthesis and biological evaluation of some novel pyrazole, isoxazole, benzoxazepine, benzothiazepine and benzodiazepine derivatives bearing an aryl sulfonate moiety as antimicrobial and anti-inflammatory agents. Arab J Chem. 2015;12:2091–7. [Google Scholar]
- 47.Viveka S, Dinesha, Madhu LN, Nagaraja GK. Synthesis of new pyrazole derivatives via multicomponent reaction and evaluation of their antimicrobial and antioxidant activities. Monatsh Chem. 2015;146:1547–55. [Google Scholar]
- 48.Sallam HA, Elgubbi AS, El-Helw EAE. Synthesis and antioxidant screening of new 2-cyano-3-(1,3-diphenyl-1H-pyrazol-4-yl)acryloyl amide derivatives and some pyrazole-based heterocycles. Synth Commun. 2020;50:2066–77. [Google Scholar]
- 49.Bellam M, Gundluru M, Sarva S, Chadive S, Netala VR, Tartte V, et al. Synthesis and antioxidant activity of some new N-alkylated pyrazole-containing benzimidazoles. Chem Heterocycl Compd. 2017;53:173–8. [Google Scholar]
- 50.Kaushik D, Khan SA, Chawla G, Kumar S. N’-[(5-chloro-3-methyl-1-phenyl-1H-pyrazol-4-yl)methylene] 2/4-substituted hydrazides: synthesis and anticonvulsant activity. Eur J Med Chem. 2010;45:3943–9. 10.1016/J.EJMECH.2010.05.049. [DOI] [PubMed] [Google Scholar]
- 51.Jain M, Sakhuja R, Khanna P, Bhagat S, Jain S. A facile synthesis of novel unsymmetrical bis-spiro– 2, 4’-diones. Arkivoc. 2008;xv:54–64. http://www.arkat-usa.org/get-file/25953/. Accessed 10 Aug 2015.
- 52.Yang GY, Oh K-A, Park N-J, Jung Y-S. New oxime reactivators connected with CH2O(CH2)nOCH2 linker and their reactivation potency for organophosphorus agents-inhibited acetylcholinesterase. Bioorg Med Chem. 2007;15:7704–10. 10.1016/j.bmc.2007.08.056. [DOI] [PubMed] [Google Scholar]
- 53.Di Giacomo B, Bedini A, Spadoni G, Tarzia G, Fraschini F, Pannacci M, et al. Synthesis and biological activity of new melatonin dimeric derivatives. Bioorg Med Chem. 2007;15:4643–50. 10.1016/j.bmc.2007.03.080. [DOI] [PubMed] [Google Scholar]
- 54.Antonini I, Polucci P, Magnano A, Gatto B, Palumbo M, Menta E, et al. Design, synthesis, and biological properties of new bis(acridine-4-carboxamides) as anticancer agents. J Med Chem. 2003;46:3109–15. 10.1021/jm030820x. [DOI] [PubMed] [Google Scholar]
- 55.Antonini I, Polucci P, Magnano A, Sparapani S, Martelli S. Rational design, synthesis, and biological evaluation of bis(pyrimido[5,6,1-de]acridines) and bis(pyrazolo[3,4,5-kl]acridine-5-carboxamides) as new anticancer agents. J Med Chem. 2004;47:5244–50. 10.1021/jm049706k. [DOI] [PubMed] [Google Scholar]
- 56.Wang C, Jung G-Y, Hua Y, Pearson C, Bryce MR, Petty MC, et al. An efficient pyridine- and oxadiazole-containing hole-blocking material for Organic Light-Emitting diodes: synthesis, Crystal structure, and device performance. Chem Mater. 2001;13:1167–73. 10.1021/cm0010250. [Google Scholar]
- 57.Wang C, Jung G-Y, Batsanov AS, Bryce MR, Petty MC. New electron-transporting materials for light emitting diodes: 1,3,4-oxadiazole–pyridine and 1,3,4-oxadiazole–pyrimidine hybrids. J Mater Chem. 2002;12:173–80. 10.1039/b106907c. [Google Scholar]
- 58.He F, Li X, Huo C, Chu S, Cui Z, Li Y, et al. Evaluation of fluorene-caused ecotoxicological responses and the mechanism underlying its toxicity in Eisenia fetida: multi-level analysis of biological organization. J Hazard Mater. 2022;437:129342. [DOI] [PubMed] [Google Scholar]
- 59.Lu H, Deng C, Yu Z, Zhang D, Li W, Huang J, et al. Synergistic degradation of fluorene in soil by dielectric barrier discharge plasma combined with P25/NH2-MIL-125(Ti). Chemosphere. 2022;296:133950. [DOI] [PubMed] [Google Scholar]
- 60.Peiffer J, Grova N, Hidalgo S, Salquèbre G, Rychen G, Bisson JF, et al. Behavioral toxicity and physiological changes from repeated exposure to fluorene administered orally or intraperitoneally to adult male Wistar rats: a dose–response study. Neurotoxicology. 2016;53:321–33. [DOI] [PubMed] [Google Scholar]
- 61.Huisman HO. Approaches to total synthesis of Heterocyclic Steroidal systems. Angew Chem Int Ed. 1971;10:450–9. 10.1002/ANIE.197104501. [Google Scholar]
- 62.Engel CR, Roy Chowdhury MN. Steroids and related products. XXVII. The synthesis of 11-oxa steroids. I. 11-oxaprogesterone. Tetrahedron Lett. 1968;9:2107–11. [DOI] [PubMed] [Google Scholar]
- 63.Helmy MT, Sroor FM, Mahrous KF, Mahmoud K, Hassaneen HM, Saleh FM, et al. Anticancer activity of novel 3-(furan-2-yl)pyrazolyl and 3-(thiophen-2-yl)pyrazolyl hybrid chalcones: synthesis and in vitro studies. Arch Pharm (Weinheim). 2022;355:e2100381. 10.1002/ardp.202100381. [DOI] [PubMed] [Google Scholar]
- 64.Kamel MG, Sroor FM, Othman AM, Mahrous KF, Saleh FM, Hassaneen HM, et al. Structure-based design of novel pyrazolyl–chalcones as anti-cancer and antimicrobial agents: synthesis and in vitro studies. Monatsh Chem. 2022;153:211–21. 10.1007/s00706-021-02886-5. [Google Scholar]
- 65.Ibrahim YA, Abbas AA, Elwahy AHM. Selective synthesis and structure of 2-N-and 3-S-glucosyl-1, 2, 4-triazoles of potential biological interest. Carbohydr Lett. 1999;3:331–8. [Google Scholar]
- 66.Mekky AEM, Elwahy AHM. Synthesis of Novel Benzo-substituted macrocyclic ligands containing thienothiophene subunits. J Heterocycl Chem. 2014;51:E34–41. [Google Scholar]
- 67.Diab HM, Abdelhamid IA, Elwahy AHM. ZnO-Nanoparticles-Catalyzed synthesis of poly(tetrahydrobenzimidazo[2,1- b ]quinazolin-1(2 H)-ones) as novel multi-armed molecules. Synlett. 2018;29:1627–33. [Google Scholar]
- 68.Abdella AM, Mohamed MF, Mohamed AF, Elwahy AHM, Abdelhamid IA. Novel bis(dihydropyrano[3,2-c]chromenes): synthesis, Antiproliferative Effect and Molecular Docking Simulation. J Heterocycl Chem. 2018;55:498–507. [Google Scholar]
- 69.Abdelhamid IA. Synthesis of novel spiro cyclic 2-oxindole derivatives of 6-amino-4H-pyridazine via [3 + 3] atom combination utilizing chitosan as a catalyst. Synlett. 2009;:625–7.
- 70.Hamed AA, Ali EA, Abdelhamid IA, Saad GR, Elsabee MZ. Synthesis of novel chitosan-Schiff bases nanoparticles for high efficiency Helicobacter pylori inhibition. Int J Biol Macromol. 2024;274:133499. 10.1016/J.IJBIOMAC.2024.133499. [DOI] [PubMed] [Google Scholar]
- 71.Abdelwahab RE, Ragheb MA, Elwahy AHM, Abdelhamid IA, Abdelmoniem AM. Conjugate and regiochemical addition of aminoazoles to 2-(4-(2,2-dicyanovinyl)phenoxy)-N-arylacetamide affording fused pyrimidines linked to phenoxy-N-arylacetamide: antibacterial activity, molecular docking, and DNA binding studies. J Mol Struct. 2024;1307:137946. 10.1016/j.molstruc.2024.137946. [Google Scholar]
- 72.Salem ME, El-Gabry YA, Abdelhamid IA, Elwahy AHM, Zaki MEA, Diab HM. Synthesis of Novel Diphenyl Ether-based Bis-Heterocycles as Novel Hybrid molecules via Michael and other Cyclocondensation reactions. ACS Omega. 2024;9:4073–84. 10.1021/acsomega.3c09081. [DOI] [PMC free article] [PubMed] [Google Scholar]
- 73.El-Gabry YA, Salem ME, Ibrahim NS, Elwahy AHM, Abdelhamid IA, Diab HM. Novel diphenyl ether-heterocycles hybrids: synthesis via Hantzsch and Biginelli reactions, molecular docking simulation, and antimicrobial activities. J Mol Struct. 2024;1296:136857. 10.1016/j.molstruc.2023.136857. [Google Scholar]
- 74.Ibrahim NS, Sayed HA, Sharaky M, Diab HM, Elwahy AHM, Abdelhamid IA. Synthesis, cytotoxicity, anti-inflammatory, anti-metastatic and anti-oxidant activities of novel chalcones incorporating 2-phenoxy-N-arylacetamide and thiophene moieties: induction of apoptosis in MCF7 and HEP2 cells. Naunyn Schmiedebergs Arch Pharmacol. 2024;397:10091–107. 10.1007/s00210-024-03255-9. [DOI] [PMC free article] [PubMed] [Google Scholar]
- 75.Abdelhamid IA, Darweesh AF, Elwahy AHM. Synthesis and characterization of poly(2,6-dimethyl-4-phenyl-1,4-dihydropyridinyl)arenes as novel multi-armed molecules. Tetrahedron Lett. 2015;56:7085–8. [Google Scholar]
- 76.Abdelmoniem AM, Abdelhamid IA, Elwahy AHM, Abdelrahman MGM, Hassaneen HM, Teleb MAM. Synthesis of novel bis(spirocyclic-2-oxindole)-tethered 10b-azachrysene or 10a-azaphenanthrene systems via a Hantzsch-like reaction. Tetrahedron. 2024;162:134125. 10.1016/j.tet.2024.134125. [Google Scholar]
- 77.Saleh FM, Hassaneen HM, Abdelhamid IA, Mohamed Teleb MA. Synthesis of novel spirocyclic 2-oxindole tethered to 2′-(3-(furan-2-yl)-1H-pyrazole-4-carbonyl)-hexahydropyrrolizine via 1,3-dipolar cycloaddition of the chalcone with azomethine ylide: reaction of pyrazolyl-enaminone towards some heteroaromatic amines. Tetrahedron Lett. 2024;137. 10.1016/j.tetlet.2024.154957. December 2023:154957.
- 78.Abdelaal N, Ragheb MA, Hassaneen HM, Elzayat EM, Abdelhamid IA. Design, in silico studies and biological evaluation of novel chalcones tethered triazolo[3,4-a]isoquinoline as EGFR inhibitors targeting resistance in non-small cell lung cancer. Sci Rep. 2024;14:26647. https://www.nature.com/articles/s41598-024-76459-x. [DOI] [PMC free article] [PubMed] [Google Scholar]
- 79.Elgamal AM, Abobakr E, Saad GR, Abdelhamid IA, Elsabee MZ, Hamed AA. Biologically active ionic chitosan Schiff base nanocomposites: synthesis, characterization and antimicrobial activity against Helicobacter pylori. Int J Biol Macromol. 2024;282:137321. 10.1016/j.ijbiomac.2024.137321. [DOI] [PubMed] [Google Scholar]
- 80.Barakat K, Ragheb MA, Soliman MH, Abdelmoniem AM, Abdelhamid IA. Novel thiazole– based cyanoacrylamide derivatives: DNA cleavage, DNA / BSA binding properties and their anticancer behaviour against colon and breast cancer cells. BMC Chem. 2024;18:183. 10.1186/s13065-024-01284-2. [DOI] [PMC free article] [PubMed] [Google Scholar]
- 81.Ibrahim NS, Mohamed MF, Elwahy AHM, Abdelhamid IA. Biological activities and Docking studies on Novel Bis 1,4-DHPS linked to Arene Core via Ether or Ester Linkage. Lett Drug Des Discov. 2018;15:1036–45. [Google Scholar]
- 82.Abdelmoniem AM, Salaheldin TA, Abdelhamid IA, Elwahy AHM. New Bis(dihydropyridine-3,5-dicarbonitrile) derivatives: Green Synthesis and cytotoxic activity evaluation. J Heterocycl Chem. 2017;54:2670–7. [Google Scholar]
- 83.Abdelmoniem AM, Ghozlan SAS, Abdelmoniem DM, Elwahy AHM, Abdelhamid IA. Facile One-pot, three-component synthesis of Novel Bis-heterocycles incorporating 5H-chromeno[2,3-b]pyridine-3-carbonitrile derivatives. J Heterocycl Chem. 2017;54:2844–9. [Google Scholar]
- 84.Ghozlan SAS, Abdelmoniem AM, Abdelhamid IA. Chemistry of Azaenamines. Curr Org Chem. 2011;15:3098–119. [Google Scholar]
- 85.Abdella AM, Abdelmoniem AM, Ibrahim NS, El-Hallouty SM, Abdelhamid IA, Elwahy AHM. Synthesis, cytotoxicity and molecular Docking Simulation of Novel bis-1,4-Dihydropyridines Linked to Aliphatic or Arene Core via Amide or Ester-Amide linkages. Mini Rev Med Chem. 2019;20:801–16. 10.2174/1389557519666190919160019. [DOI] [PubMed] [Google Scholar]
- 86.Elwahy A, Shaaban M. Synthesis of pyrido- and pyrimido-fused heterocycles by multi-component reactions (part 3). Curr Org Synth. 2014;11:835–73. [Google Scholar]
- 87.Salem ME, Darweesh AF, Farag AM, Elwahy AHM. 2-Bromo-1-(1H-pyrazol-4-yl)ethanone: versatile precursors for novel mono-, bis- and poly{6-(1H-pyrazol-4-yl)-[1,2,4]triazolo[3,4-b][1,3,4]thiadiazines}. Tetrahedron. 2016;72:712–9. [Google Scholar]
- 88.Laohapaisan P, Chuangsoongnern P, Tummatorn J, Thongsornkleeb C, Ruchirawat S. Divergent synthesis of 3-Hydroxyfluorene and 4-Azafluorene derivatives from Ortho-Alkynylarylketones. J Org Chem. 2019;84:14451–60. 10.1021/ACS.JOC.9B01825/SUPPL_FILE/JO9B01825_SI_001.PDF. [DOI] [PubMed] [Google Scholar]
- 89.Wu YC, Duh CY, Wang SK, Chen KS, Yang TH. Two new natural azafluorene alkaloids and a cytotoxic aporphine alkaloid from polyalthia longifolia. J Nat Prod. 1990;53:1327–31. 10.1021/NP50071A028/ASSET/NP50071A028.FP.PNG_V03. [DOI] [PubMed] [Google Scholar]
- 90.Prachayasittikul S, Manam P, Chinworrungsee M, Isarankura-Na-ayudhya C, Ruchirawat S, Prachayasittikul V. Bioactive azafluorenone alkaloids from Polyalthia debilis (pierre) finet & Gagnep. Molecules. 2009;14:4414–24. 10.3390/molecules14114414. [DOI] [PMC free article] [PubMed] [Google Scholar]
- 91.Venkateshan M, Muthu M, Suresh J, Ranjith Kumar R. Azafluorene derivatives as inhibitors of SARS CoV-2 RdRp: synthesis, physicochemical, quantum chemical, modeling and molecular docking analysis. J Mol Struct. 2020;1220:128741. [DOI] [PMC free article] [PubMed] [Google Scholar]
- 92.Hranjec M, Pavlović G, Karminski-Zamola G. Synthesis, crystal structure determination and antiproliferative activity of novel 2-amino-4-aryl-4,10-dihydro[1,3,5]triazino[1,2-a]benzimidazoles. J Mol Struct. 2012;1007:242–51. [Google Scholar]
Associated Data
This section collects any data citations, data availability statements, or supplementary materials included in this article.
Supplementary Materials
Data Availability Statement
All data generated or analyzed during this study are included in this published article and its supplementary information file. Data available at request (Ismail A. Abdelhamid, ismail_shafy@yahoo.com, ismail_shafy@cu.edu.eg).